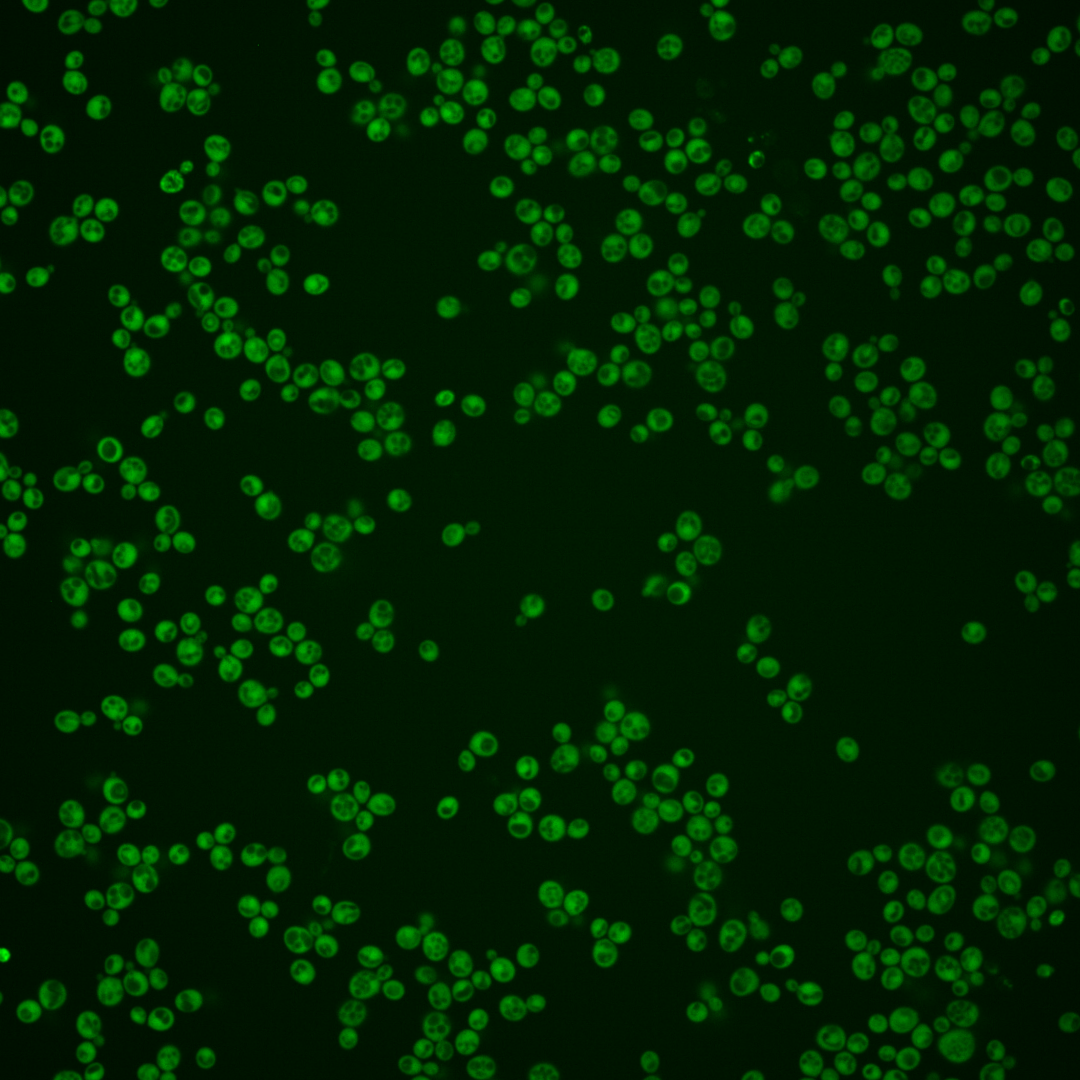
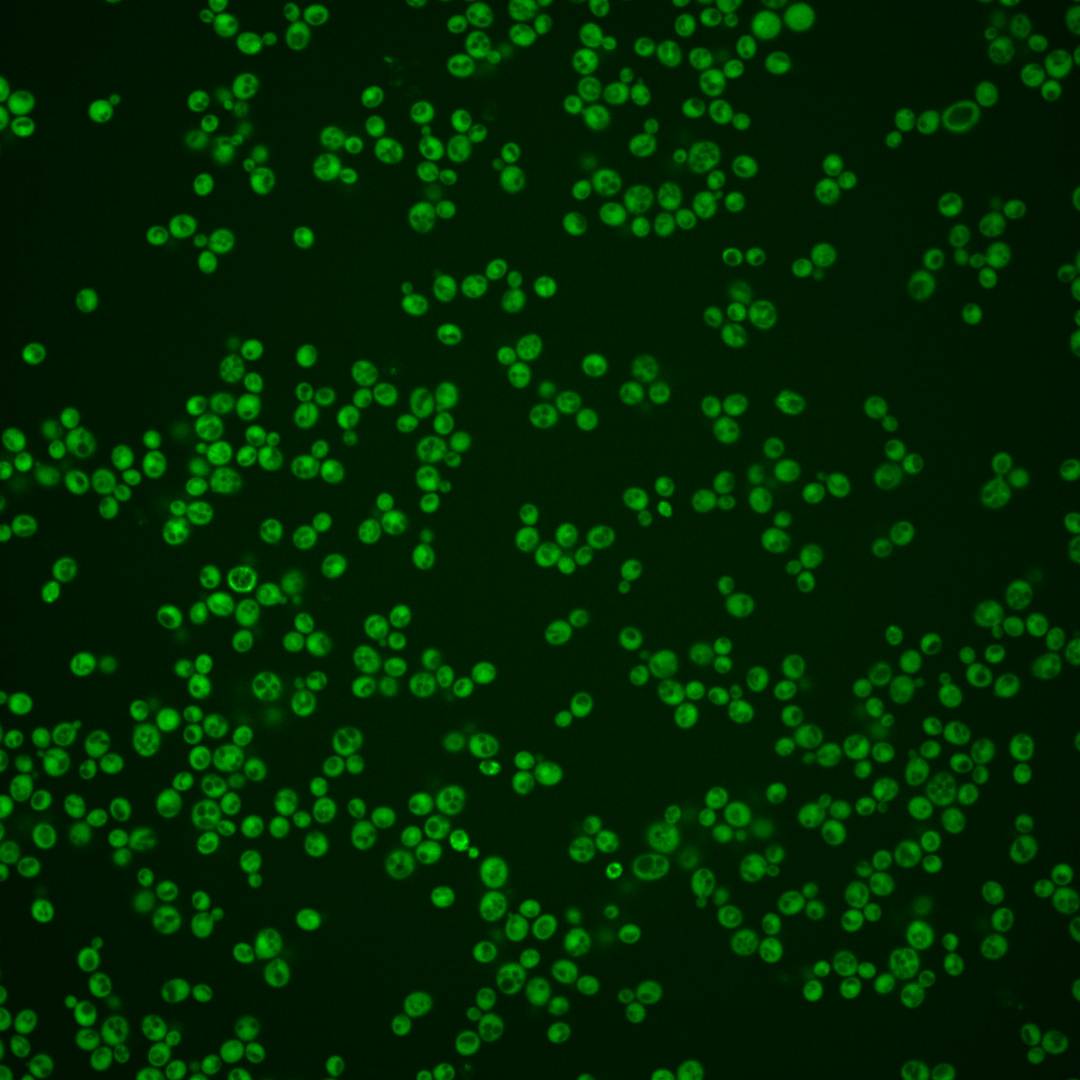
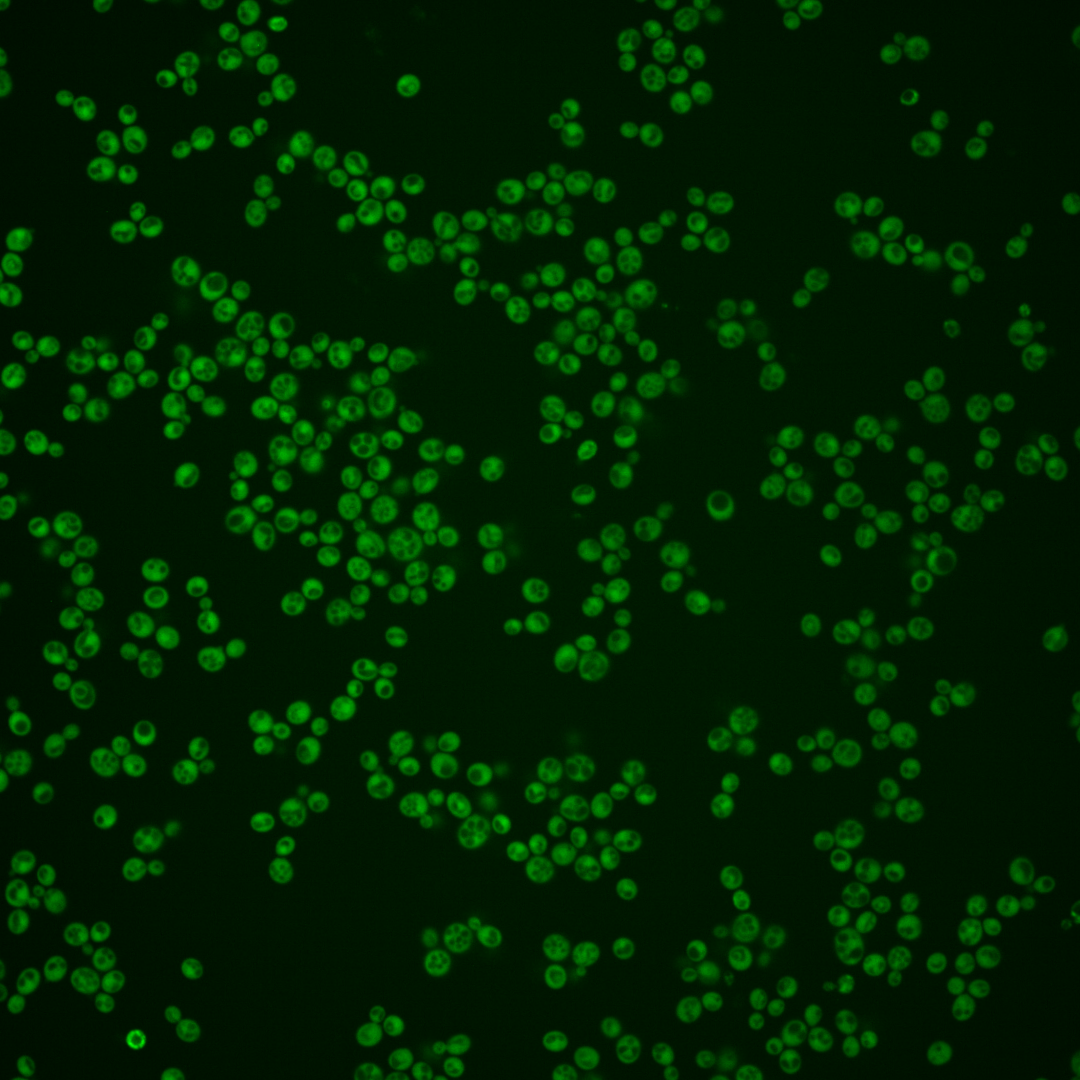
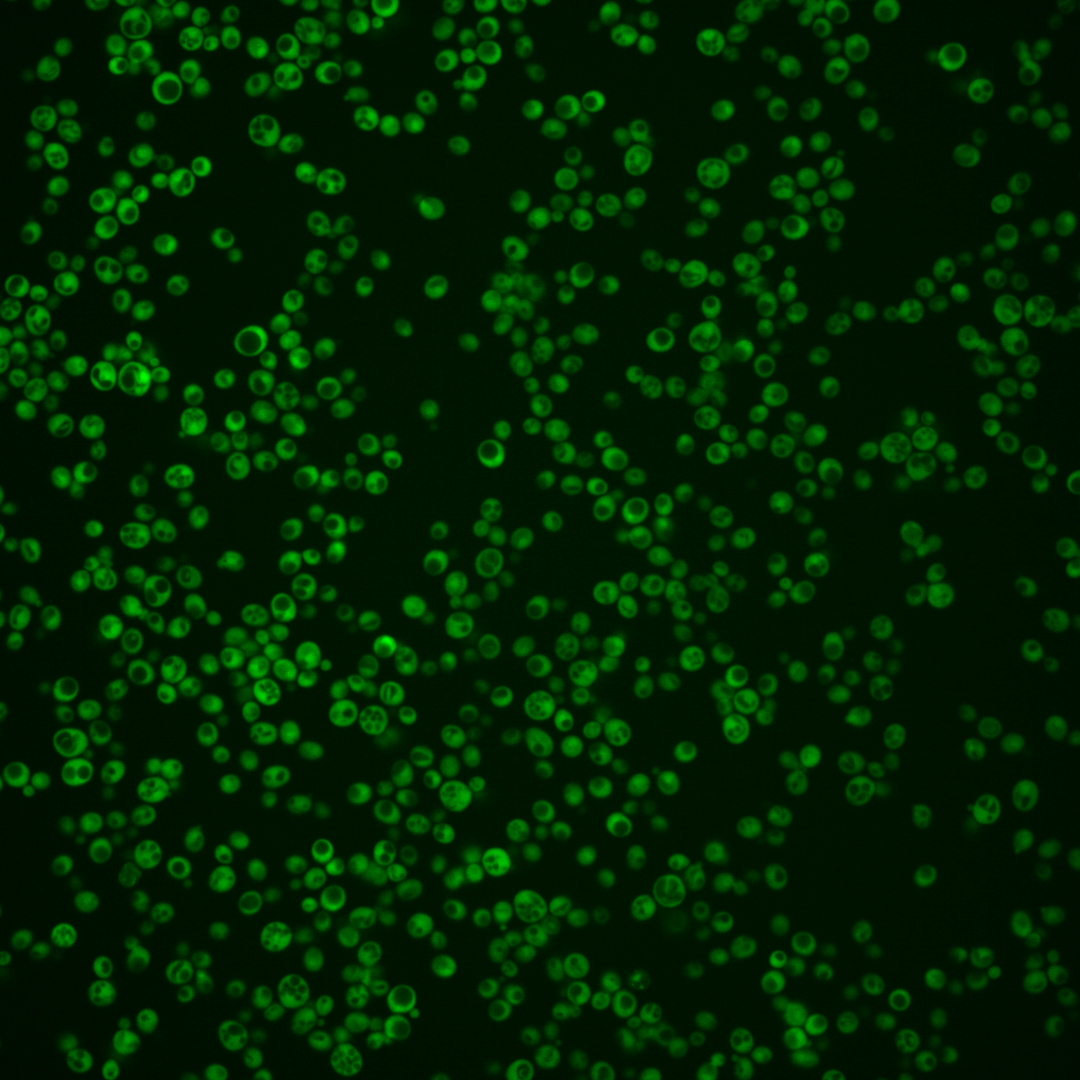
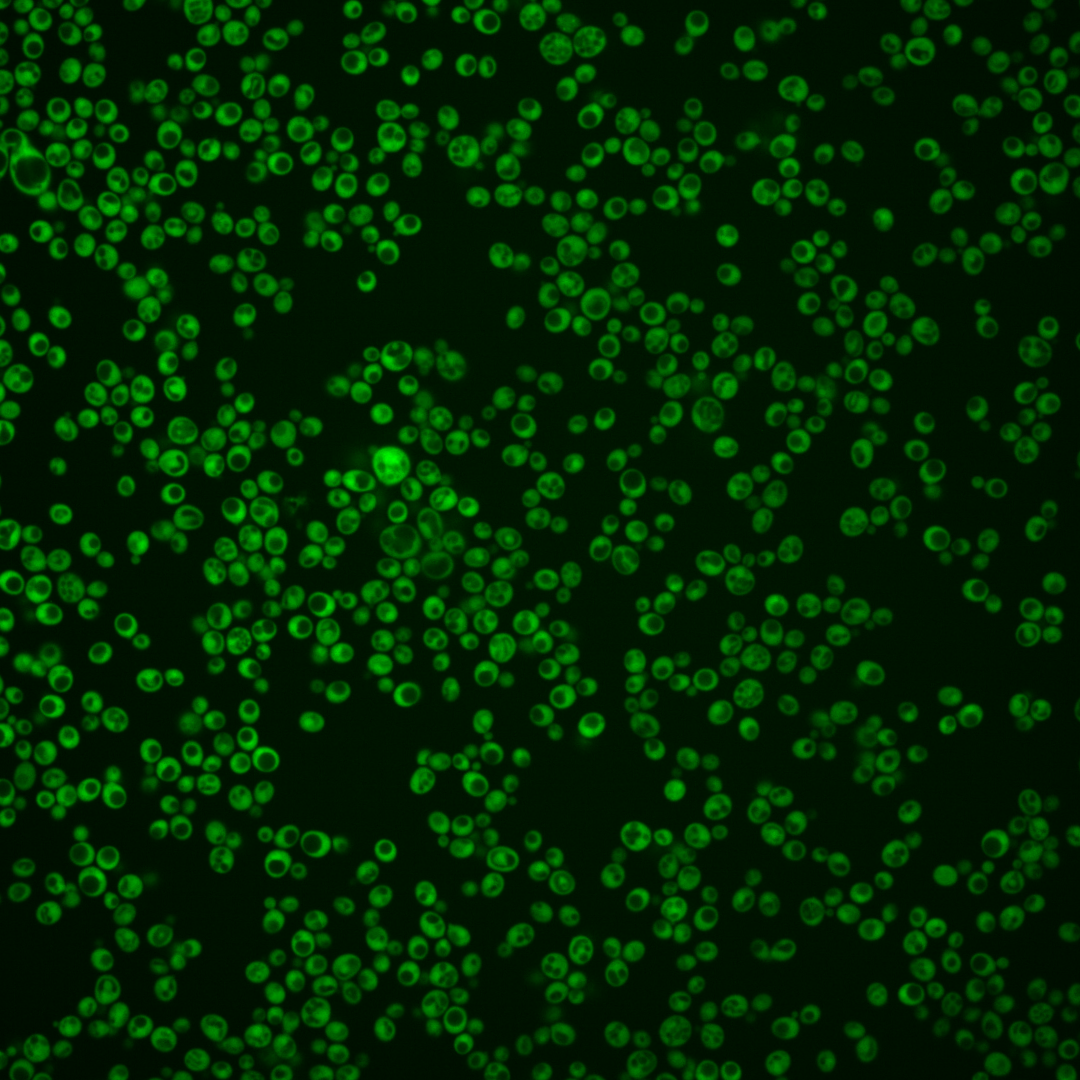
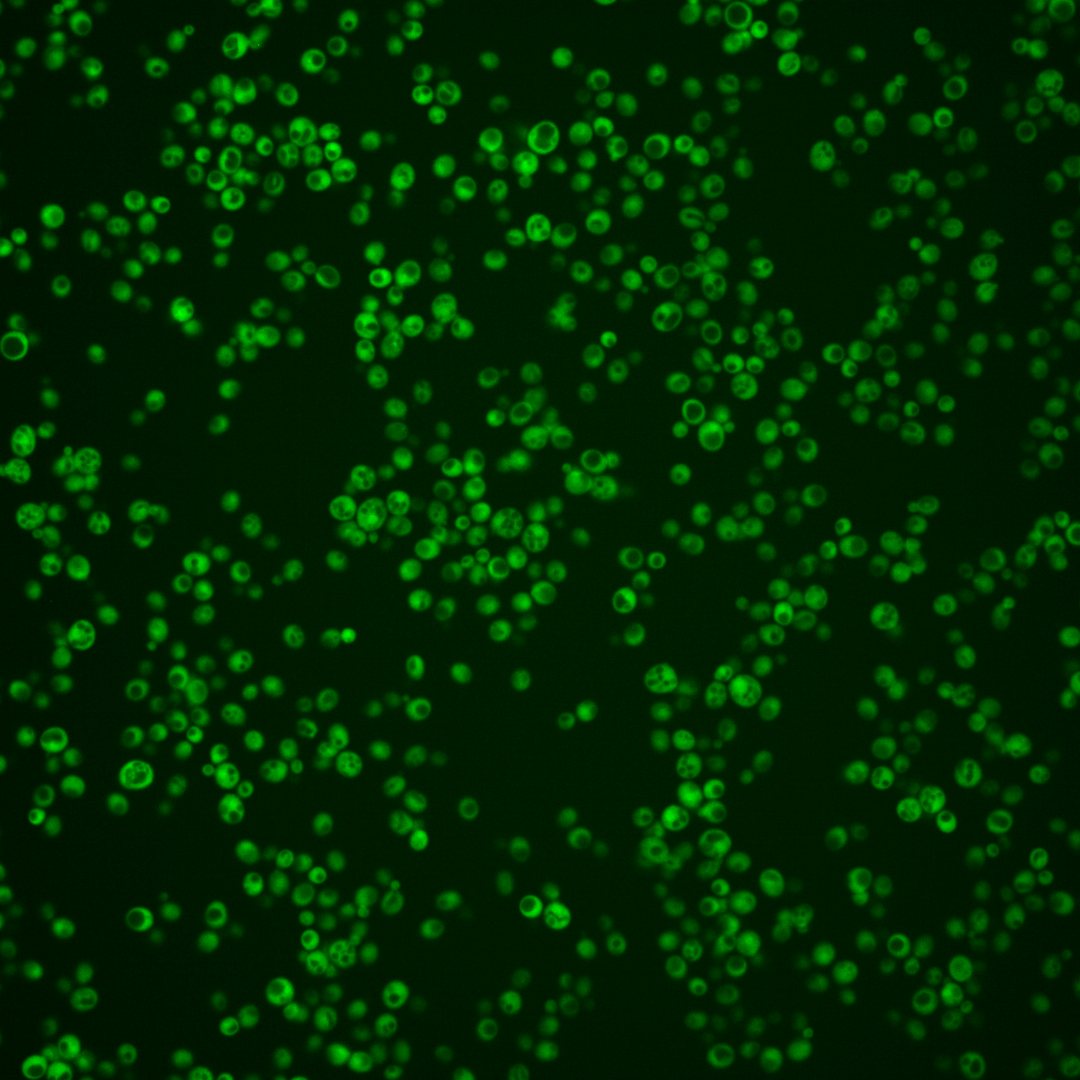
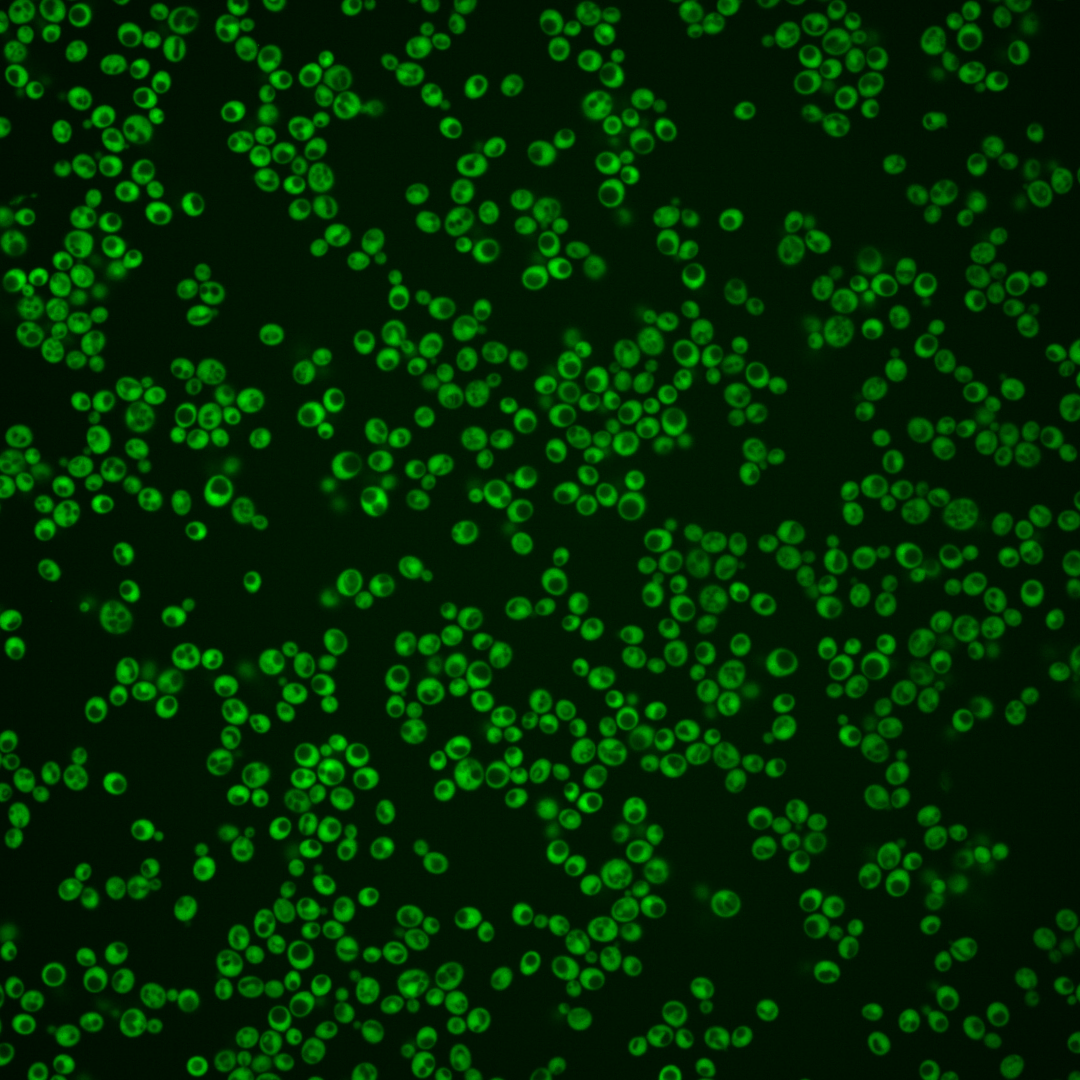

| Standard name | |
|---|---|
| Human Ortholog | |
| Description | Putative protein of unknown function; functions together with HAM1 to mediate resistance to 5-FU; specifically reduces the incorporation of 5-FU into RNA, without affecting uptake or incorporation of uracil into RNA; proposed to be involved in the metabolism of purine and pyrimidine base analogues; deletion mutants are sensitive to HAP and AHA |
Micrographs




















































































Sub-cellular Localization
Yeast GFP Assignment
Protein Abundance
Localization Change
External localization resources
| ensLOC | DeepLoc | |||||||||||||||||||||||
|---|---|---|---|---|---|---|---|---|---|---|---|---|---|---|---|---|---|---|---|---|---|---|---|---|
| Localization | WT1 | WT2 | WT3 | RAP60 | RAP140 | RAP220 | RAP300 | RAP380 | RAP460 | RAP540 | RAP620 | RAP700 | HU80 | HU120 | HU160 | rpd3Δ_1 | rpd3Δ_2 | rpd3Δ_3 | WT1 | WT2 | WT3 | AF100 | AF140 | AF180 |
| Cortical Patches | 0 | 0 | 0 | 0 | 0 | 1 | 1 | 2 | 1 | 2 | 3 | 5 | 0 | 0 | 0 | 0 | 0 | 0 | 0 | 0 | 0 | 0 | 0 | 0 |
| Bud | 0 | 0 | 0 | 0 | 0 | 0 | 1 | 0 | 5 | 1 | 0 | 1 | 0 | 0 | 0 | 1 | 0 | 0 | 0 | 0 | 0 | 0 | 1 | 1 |
| Bud Neck | 0 | 0 | 0 | 0 | 0 | 0 | 0 | 0 | 0 | 0 | 0 | 0 | 0 | 0 | 0 | 0 | 0 | 0 | 0 | 0 | 0 | 0 | 0 | 0 |
| Bud Site | 0 | 0 | 0 | 0 | 0 | 0 | 0 | 0 | 0 | 0 | 0 | 0 | 0 | 0 | 0 | 0 | 0 | 0 | – | – | – | – | – | – |
| Cell Periphery | 1 | 1 | 4 | 2 | 4 | 10 | 8 | 14 | 6 | 7 | 5 | 16 | 3 | 2 | 2 | 2 | 2 | 2 | 0 | 0 | 0 | 0 | 0 | 0 |
| Cytoplasm | 94 | 176 | 291 | 259 | 337 | 336 | 337 | 366 | 158 | 222 | 198 | 311 | 210 | 372 | 408 | 227 | 304 | 266 | 114 | 174 | 276 | 265 | 339 | 401 |
| Endoplasmic Reticulum | 0 | 1 | 1 | 2 | 8 | 10 | 20 | 24 | 8 | 13 | 6 | 21 | 1 | 2 | 1 | 5 | 9 | 8 | 0 | 0 | 2 | 1 | 1 | 2 |
| Endosome | 0 | 0 | 0 | 0 | 0 | 0 | 0 | 0 | 0 | 0 | 0 | 0 | 0 | 0 | 0 | 0 | 0 | 0 | 0 | 0 | 0 | 1 | 1 | 2 |
| Golgi | 0 | 0 | 1 | 0 | 0 | 1 | 0 | 2 | 1 | 1 | 0 | 0 | 0 | 0 | 0 | 1 | 0 | 0 | 0 | 0 | 1 | 0 | 1 | 0 |
| Mitochondria | 0 | 1 | 0 | 0 | 0 | 2 | 1 | 1 | 18 | 10 | 11 | 18 | 0 | 0 | 0 | 3 | 3 | 1 | 0 | 0 | 0 | 1 | 2 | 0 |
| Nucleus | 1 | 1 | 0 | 4 | 7 | 8 | 7 | 8 | 1 | 6 | 6 | 10 | 2 | 5 | 3 | 7 | 2 | 0 | 1 | 1 | 0 | 2 | 6 | 3 |
| Nuclear Periphery | 0 | 0 | 0 | 0 | 0 | 0 | 0 | 0 | 1 | 0 | 0 | 0 | 0 | 0 | 0 | 0 | 0 | 0 | 0 | 0 | 1 | 0 | 1 | 0 |
| Nucleolus | 0 | 0 | 0 | 0 | 0 | 0 | 0 | 0 | 0 | 0 | 0 | 0 | 0 | 0 | 0 | 1 | 0 | 1 | 0 | 0 | 0 | 0 | 0 | 0 |
| Peroxisomes | 0 | 0 | 0 | 0 | 0 | 0 | 0 | 0 | 0 | 0 | 0 | 0 | 0 | 0 | 0 | 0 | 0 | 0 | 0 | 0 | 0 | 0 | 0 | 0 |
| SpindlePole | 0 | 0 | 0 | 0 | 0 | 0 | 0 | 0 | 0 | 0 | 0 | 0 | 0 | 0 | 0 | 0 | 0 | 0 | 0 | 0 | 0 | 0 | 0 | 0 |
| Vac/Vac Membrane | 1 | 0 | 1 | 2 | 11 | 21 | 45 | 68 | 59 | 41 | 63 | 96 | 9 | 1 | 12 | 3 | 6 | 19 | 1 | 1 | 0 | 0 | 5 | 1 |
| Unique Cell Count | 96 | 177 | 293 | 264 | 353 | 369 | 401 | 466 | 241 | 296 | 276 | 451 | 217 | 377 | 414 | 232 | 306 | 282 | 118 | 178 | 286 | 277 | 367 | 416 |
| Labelled Cell Count | 97 | 180 | 298 | 269 | 367 | 389 | 420 | 485 | 258 | 303 | 292 | 478 | 225 | 382 | 426 | 250 | 326 | 297 | 118 | 178 | 286 | 277 | 367 | 416 |
Yeast GFP Assignment
Protein Abundance
| Screen | WT1 | WT2 | WT3 | RAP60 | RAP140 | RAP220 | RAP300 | RAP380 | RAP460 | RAP540 | RAP620 | RAP700 | HU80 | HU120 | HU160 | rpd3Δ_1 | rpd3Δ_2 | rpd3Δ_3 | AF100 | AF140 | AF180 |
|---|---|---|---|---|---|---|---|---|---|---|---|---|---|---|---|---|---|---|---|---|---|
| Mean Cell GFP Intensity (1e-4) | 14.8 | 10.6 | 14.2 | 13.6 | 14.9 | 13.2 | 13.4 | 12.8 | 11.8 | 12.5 | 12.1 | 12.4 | 15.8 | 16.1 | 16.2 | 14.7 | 19.0 | 19.6 | 14.8 | 14.9 | 15.6 |
| Std Deviation (1e-4) | 2.7 | 1.8 | 1.9 | 2.0 | 2.2 | 2.0 | 2.4 | 2.2 | 2.3 | 2.4 | 2.3 | 2.5 | 2.6 | 2.4 | 2.2 | 3.6 | 4.5 | 5.3 | 2.4 | 3.2 | 2.8 |
| Intensity Change (Log2) | – | – | – | -0.06 | 0.08 | -0.1 | -0.08 | -0.15 | -0.26 | -0.18 | -0.23 | -0.19 | 0.16 | 0.18 | 0.19 | 0.05 | 0.42 | 0.47 | 0.06 | 0.07 | 0.14 |
Localization Change
| Localization | RAP60 | RAP140 | RAP220 | RAP300 | RAP380 | RAP460 | RAP540 | RAP620 | RAP700 | HU80 | HU120 | HU160 | rpd3Δ_1 | rpd3Δ_2 | rpd3Δ_3 |
|---|---|---|---|---|---|---|---|---|---|---|---|---|---|---|---|
| Cortical Patches | 0 | 0 | 0 | 0 | 0 | 0 | 0 | 0 | 0 | 0 | 0 | 0 | 0 | 0 | 0 |
| Bud | 0 | 0 | 0 | 0 | 0 | 0 | 0 | 0 | 0 | 0 | 0 | 0 | 0 | 0 | 0 |
| Bud Neck | 0 | 0 | 0 | 0 | 0 | 0 | 0 | 0 | 0 | 0 | 0 | 0 | 0 | 0 | 0 |
| Bud Site | 0 | 0 | 0 | 0 | 0 | 0 | 0 | 0 | 0 | 0 | 0 | 0 | 0 | 0 | 0 |
| Cell Periphery | 0 | 0 | 1.2 | 0.6 | 1.4 | 0 | 0.9 | 0 | 1.8 | 0 | 0 | 0 | 0 | 0 | 0 |
| Cytoplasm | -1.3 | -3.0 | -4.7 | -6.8 | -8.2 | -10.6 | -8.8 | -9.5 | -10.3 | -2.2 | -0.8 | -0.9 | -1.5 | 0 | -3.4 |
| Endoplasmic Reticulum | 0 | 0 | 0 | 3.5 | 3.6 | 0 | 3.2 | 0 | 3.4 | 0 | 0 | 0 | 0 | 0 | 0 |
| Endosome | 0 | 0 | 0 | 0 | 0 | 0 | 0 | 0 | 0 | 0 | 0 | 0 | 0 | 0 | 0 |
| Golgi | 0 | 0 | 0 | 0 | 0 | 0 | 0 | 0 | 0 | 0 | 0 | 0 | 0 | 0 | 0 |
| Mitochondria | 0 | 0 | 0 | 0 | 0 | 4.8 | 0 | 3.5 | 3.5 | 0 | 0 | 0 | 0 | 0 | 0 |
| Nucleus | 0 | 0 | 0 | 0 | 0 | 0 | 0 | 0 | 0 | 0 | 0 | 0 | 0 | 0 | 0 |
| Nuclear Periphery | 0 | 0 | 0 | 0 | 0 | 0 | 0 | 0 | 0 | 0 | 0 | 0 | 0 | 0 | 0 |
| Nucleolus | 0 | 0 | 0 | 0 | 0 | 0 | 0 | 0 | 0 | 0 | 0 | 0 | 0 | 0 | 0 |
| Peroxisomes | 0 | 0 | 0 | 0 | 0 | 0 | 0 | 0 | 0 | 0 | 0 | 0 | 0 | 0 | 0 |
| SpindlePole | 0 | 0 | 0 | 0 | 0 | 0 | 0 | 0 | 0 | 0 | 0 | 0 | 0 | 0 | 0 |
| Vacuole | 0 | 2.6 | 3.8 | 5.7 | 6.6 | 8.8 | 6.4 | 8.5 | 8.3 | 0 | 0 | 2.5 | 0 | 0 | 4.2 |
External localization resources
Images






























Protein Concentration and Protein Localization Data
| R1 | R2 | R3 | ||||||||||||||||
|---|---|---|---|---|---|---|---|---|---|---|---|---|---|---|---|---|---|---|
| G1 Pre-START | G1 Post-START | S/G2 | Metaphase | Anaphase | Telophase | G1 Pre-START | G1 Post-START | S/G2 | Metaphase | Anaphase | Telophase | G1 Pre-START | G1 Post-START | S/G2 | Metaphase | Anaphase | Telophase | |
| Concentration | 10.4643 | 11.3001 | 10.4873 | 8.4924 | 9.3791 | 10.1918 | 11.7447 | 14.7869 | 13.1625 | 12.8983 | 12.8261 | 13.3056 | 9.7864 | 11.9197 | 10.719 | 11.6224 | 8.2472 | 10.6058 |
| Actin | 0.0002 | 0.0008 | 0.0001 | 0.0007 | 0.0001 | 0.0002 | 0.0656 | 0.001 | 0.0333 | 0.0009 | 0.0002 | 0.0036 | 0.0032 | 0.0001 | 0.0006 | 0.0003 | 0.0003 | 0.0026 |
| Bud | 0.0001 | 0.0001 | 0.0001 | 0.0001 | 0.0001 | 0.0001 | 0.0009 | 0.0001 | 0.0005 | 0.0007 | 0.0001 | 0.0002 | 0.0002 | 0.0001 | 0.0005 | 0.0001 | 0.0002 | 0.0002 |
| Bud Neck | 0.0002 | 0.0002 | 0.0002 | 0.0005 | 0.0004 | 0.0006 | 0.008 | 0.0001 | 0.002 | 0.0011 | 0.0008 | 0.0009 | 0.0003 | 0.0001 | 0.0004 | 0.0003 | 0.0007 | 0.0007 |
| Bud Periphery | 0 | 0 | 0 | 0 | 0 | 0 | 0.0012 | 0.0001 | 0.0004 | 0.0003 | 0 | 0.0001 | 0.0001 | 0 | 0.0004 | 0 | 0.0001 | 0.0001 |
| Bud Site | 0.0001 | 0.0003 | 0.0001 | 0 | 0 | 0 | 0.0057 | 0.0005 | 0.0054 | 0.0008 | 0 | 0.0002 | 0.0007 | 0.0001 | 0.001 | 0.0001 | 0.001 | 0.0001 |
| Cell Periphery | 0 | 0 | 0 | 0 | 0 | 0 | 0.0003 | 0 | 0.0001 | 0 | 0 | 0 | 0 | 0 | 0.0001 | 0.0001 | 0 | 0 |
| Cytoplasm | 0.9572 | 0.9708 | 0.9654 | 0.9699 | 0.9598 | 0.9538 | 0.7936 | 0.9765 | 0.9034 | 0.9339 | 0.9885 | 0.9472 | 0.9347 | 0.99 | 0.9481 | 0.9545 | 0.8498 | 0.945 |
| Cytoplasmic Foci | 0.0007 | 0.0017 | 0.002 | 0.0011 | 0.001 | 0.0022 | 0.0197 | 0.0053 | 0.0092 | 0.0104 | 0.0014 | 0.0078 | 0.0041 | 0.0005 | 0.0079 | 0.0024 | 0.0446 | 0.0017 |
| Eisosomes | 0 | 0 | 0 | 0 | 0 | 0 | 0.0008 | 0 | 0.0001 | 0 | 0 | 0 | 0.0001 | 0 | 0 | 0 | 0 | 0 |
| Endoplasmic Reticulum | 0.0015 | 0.0006 | 0.0009 | 0.0011 | 0.0027 | 0.0038 | 0.0063 | 0.0002 | 0.0017 | 0.001 | 0.0005 | 0.0012 | 0.0015 | 0.0003 | 0.0018 | 0.0088 | 0.0008 | 0.0025 |
| Endosome | 0.0005 | 0.0013 | 0.0005 | 0.0006 | 0.0012 | 0.0032 | 0.0251 | 0.0007 | 0.0125 | 0.0296 | 0.0004 | 0.0054 | 0.0052 | 0.0001 | 0.0066 | 0.0079 | 0.0635 | 0.0037 |
| Golgi | 0 | 0.0001 | 0 | 0 | 0 | 0.0001 | 0.0146 | 0.0016 | 0.0079 | 0.0033 | 0 | 0.0048 | 0.0008 | 0 | 0.0009 | 0.0003 | 0.008 | 0.0009 |
| Lipid Particles | 0 | 0 | 0 | 0 | 0 | 0 | 0.0083 | 0.0035 | 0.0036 | 0.0003 | 0 | 0.0002 | 0.0054 | 0 | 0.0012 | 0.0012 | 0.0037 | 0 |
| Mitochondria | 0.0001 | 0.0001 | 0.0001 | 0.0002 | 0.0001 | 0.0002 | 0.012 | 0.0002 | 0.0027 | 0.0017 | 0.0001 | 0.0129 | 0.0016 | 0 | 0.0021 | 0.0001 | 0.0007 | 0.0096 |
| None | 0.0012 | 0.0008 | 0.0008 | 0.0016 | 0.0009 | 0.001 | 0.0059 | 0.0009 | 0.0013 | 0.0017 | 0.0008 | 0.0015 | 0.0038 | 0.0006 | 0.0029 | 0.0015 | 0.0009 | 0.0008 |
| Nuclear Periphery | 0.0048 | 0.0015 | 0.0026 | 0.0023 | 0.0039 | 0.005 | 0.0047 | 0.0004 | 0.0018 | 0.001 | 0.0006 | 0.0007 | 0.0046 | 0.0006 | 0.0028 | 0.0037 | 0.0014 | 0.0038 |
| Nucleolus | 0 | 0 | 0 | 0 | 0 | 0 | 0.0008 | 0.0001 | 0.0001 | 0 | 0 | 0 | 0.0004 | 0 | 0.0007 | 0 | 0.0001 | 0 |
| Nucleus | 0.0324 | 0.0206 | 0.0263 | 0.0206 | 0.0283 | 0.0281 | 0.0128 | 0.0034 | 0.009 | 0.009 | 0.0061 | 0.0095 | 0.0264 | 0.0072 | 0.0157 | 0.0156 | 0.0171 | 0.027 |
| Peroxisomes | 0 | 0 | 0.0001 | 0 | 0 | 0 | 0.0074 | 0.0018 | 0.003 | 0.0004 | 0 | 0.0031 | 0.004 | 0 | 0.0006 | 0 | 0.0033 | 0.0001 |
| Punctate Nuclear | 0.0003 | 0.0005 | 0.0005 | 0.0009 | 0.0003 | 0.0004 | 0.0041 | 0.0035 | 0.0009 | 0.0004 | 0.0002 | 0.0003 | 0.0017 | 0.0002 | 0.0014 | 0.0006 | 0.0011 | 0.0004 |
| Vacuole | 0.0006 | 0.0005 | 0.0003 | 0.0003 | 0.0008 | 0.0009 | 0.0015 | 0.0001 | 0.0007 | 0.0027 | 0.0002 | 0.0002 | 0.0009 | 0.0001 | 0.0035 | 0.0022 | 0.0024 | 0.0005 |
| Vacuole Periphery | 0.0001 | 0.0001 | 0.0001 | 0.0001 | 0.0002 | 0.0003 | 0.0008 | 0 | 0.0003 | 0.0007 | 0.0001 | 0.0001 | 0.0004 | 0 | 0.0009 | 0.0003 | 0.0003 | 0.0003 |
Sequencing Data
| R1 | R2 | |||||||||
|---|---|---|---|---|---|---|---|---|---|---|
| G1 Post-START | S/G2 | Metaphase | Anaphase | Telophase | G1 Post-START | S/G2 | Metaphase | Anaphase | Telophase | |
| Gene Expression | 35.1355 | 40.0966 | 30.7452 | 46.8791 | 48.4625 | 47.8176 | 51.3527 | 61.1104 | 70.7018 | 56.1983 |
| Translational Efficiency | 2.0774 | 1.7477 | 2.1536 | 1.708 | 1.8703 | 1.7752 | 1.7029 | 1.4408 | 1.4513 | 1.7784 |
Hit Data
| Dataset | Hit |
|---|---|
| Protein Concentration | ✘ |
| Protein Localization | ✘ |
| Gene Expression | ✘ |
| Translational Efficiency | ✘ |
Endocytosis
| Temp | Actin Patch (Sac6-tdTomato) | Cortical Patch (Sla1-GFP) | Late Endosome (Snf7-GFP) | Vacuole (Vph1-GFP) |
|---|---|---|---|---|
| 37℃ | ||||
| RT |
Cell Cycle Omics
CYCLoPs (Log1-GFP)
| Gene / Allele | Actin Patch (Sac6-tdTomato) | Cortical Patch (Sla1-GFP) | Late Endosome (Snf7-GFP) | Vacuole (Sac6-tdTomato) |
|---|
| Gene | Images |
|---|
| Gene | Images |
|---|
Images are not yet available
Images are not yet available